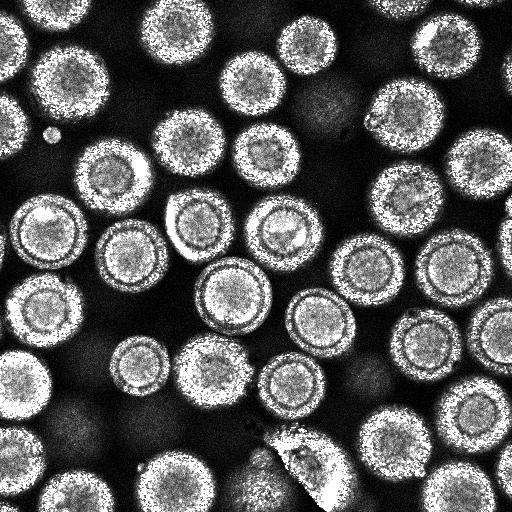

Research
Fracture and Adhesion Mechanics of Heterogeneous Materials
Interface mechanical properties have a significant effect on adhesion and fracture properties of materials. The measurement of these interface properties is critical for optimization of heterogeneous materials, particularly in additive manufacturing techniques such as 3D printing.
Our approach includes study of additive manufacturing, material characterization, experimental methods, and imaging techniques
Deformation and fracture of heterogeneous materials
Louisa Avellar
Additive manufacturing, commonly known as 3D printing, is emerging as a fabrication technique useful for manufacturing complex components, prototypes and one-off designs. One of the more recent developments in additive manufacturing is the ability to print in multiple materials simultaneously. As a result, highly heterogeneous parts tailored to their application can be easily manufactured. The aim of this work is to study the effect of heterogeneities on crack propagation. Heterogeneities influence crack advancement through two mechanisms: interface effects and local deformations. In general, material interfaces are expected to retard crack growth because the interface requires the crack to re-nucleate in order to pass through the interface. On the other hand, local deformations induced by heterogeneous material properties near the crack tip redistribute stresses at the crack tip in ways that can accelerate or retard the crack, depending on the properties and distribution of the materials involved.
Specimens are fabricated using a variety of additive manufacturing techniques including 3d printing (Stratasys Connex3) and sheet lamination. Full field displacements are calculated using Digital Image Correlation (DIC) techniques which are then used to calculate J-integrals during crack advancement.
Experimental methods for imaging and digital volume correlation of heterogeneous brittle materials
Kimberley Mac Donald
Heterogeneities in brittle materials can introduce significant fracture toughening by forcing cracks to re-nucleate as they move through the material. They can also divert cracks toward less critical areas of a structure, effectively increasing the structure’s fracture resistance. This project focuses on experimental methods for imaging and digital volume correlation (DVC) to study these effects.
The first part of this project explores method development and application for granular materials. Experimental study of force chains in three dimensions allows for validation of multiscale simulations and analytical theories for a wide variety of granular packings.

Fig 1. Click here to view the animation.
These methods are extended to the study of brittle fracture through imaging and analysis methods. They provide insight into the complex three dimensional mechanisms involved in crack propagation and microstructural heterogeneity interaction. A better understanding of these interactions will drive material design via additive manufacturing techniques.
Fig 2. Click here to view the animation.

Fig 3